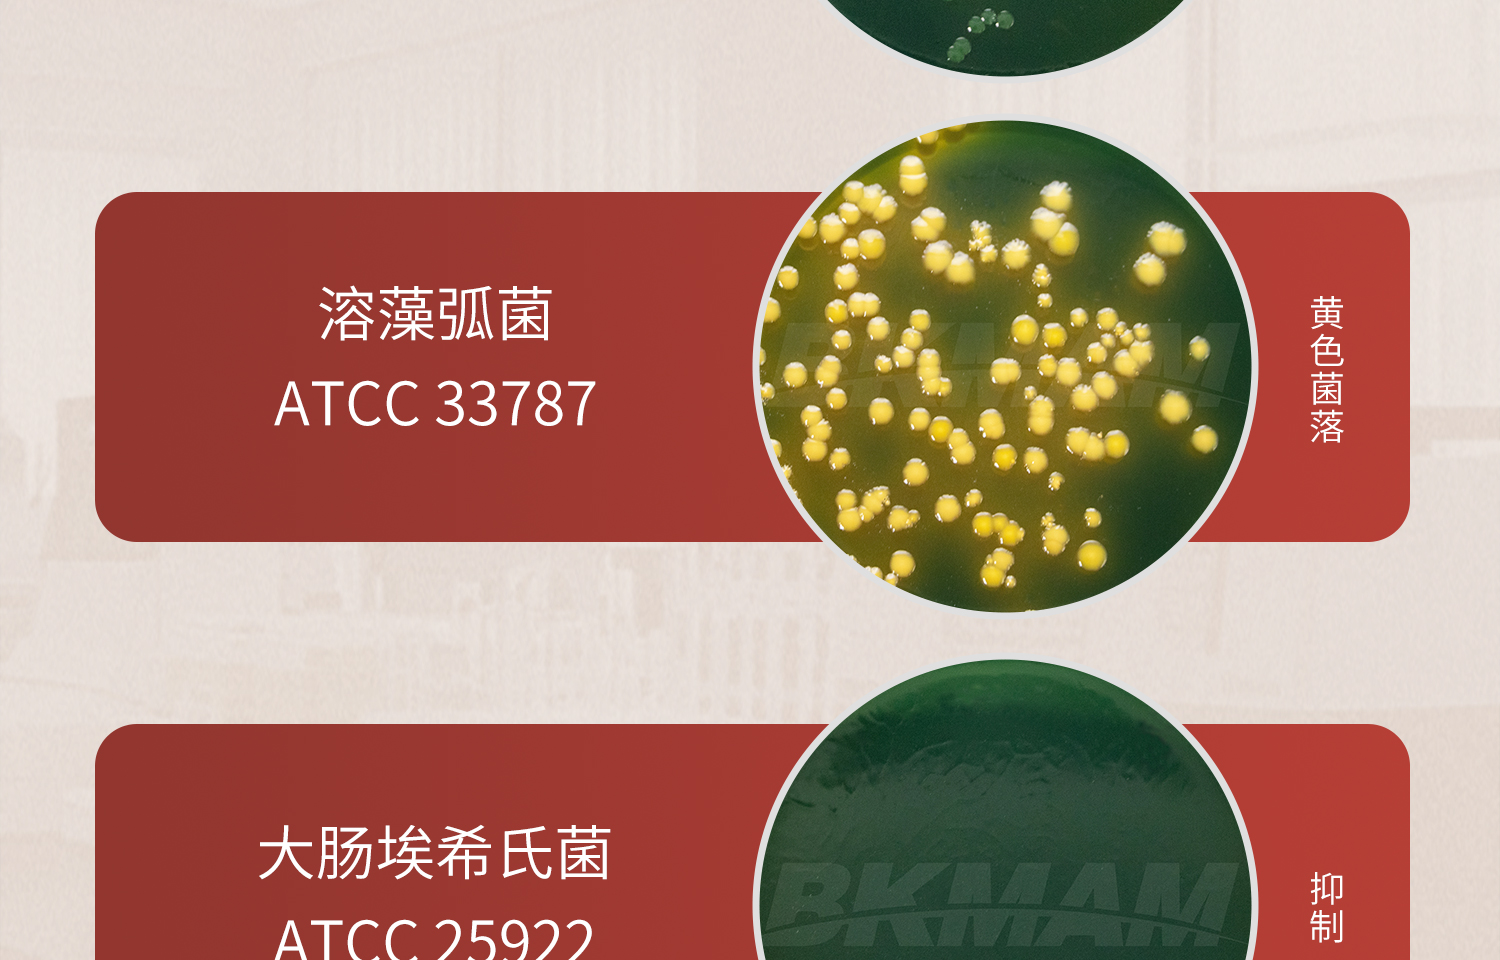
LabTCBS琼脂培养基详情_15.jpg
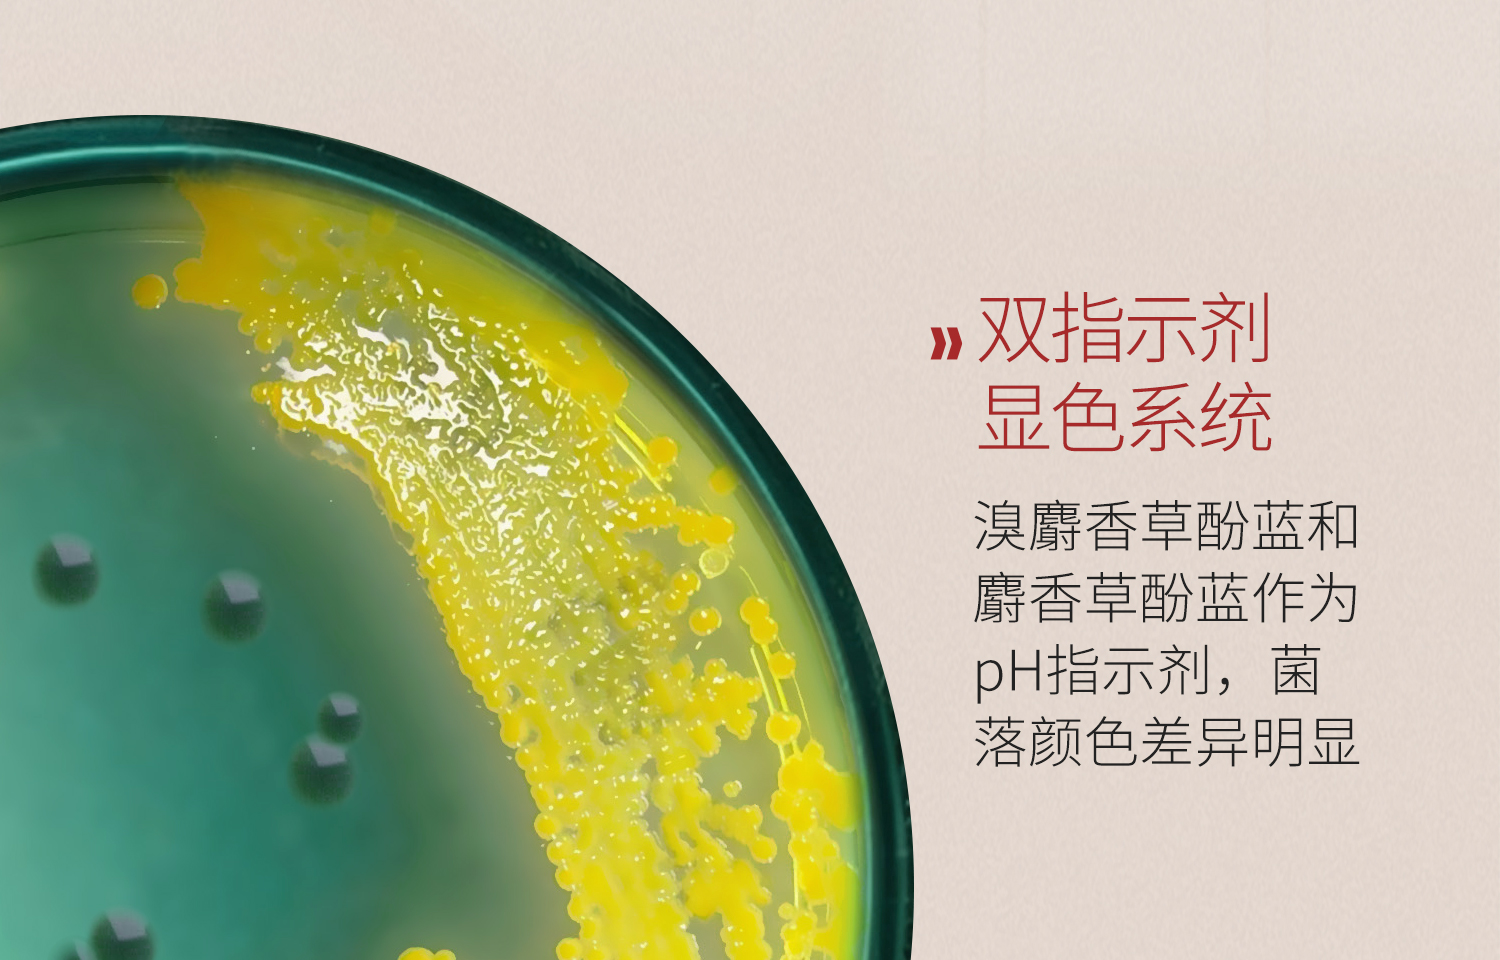
LabTCBS琼脂培养基详情_17.jpg
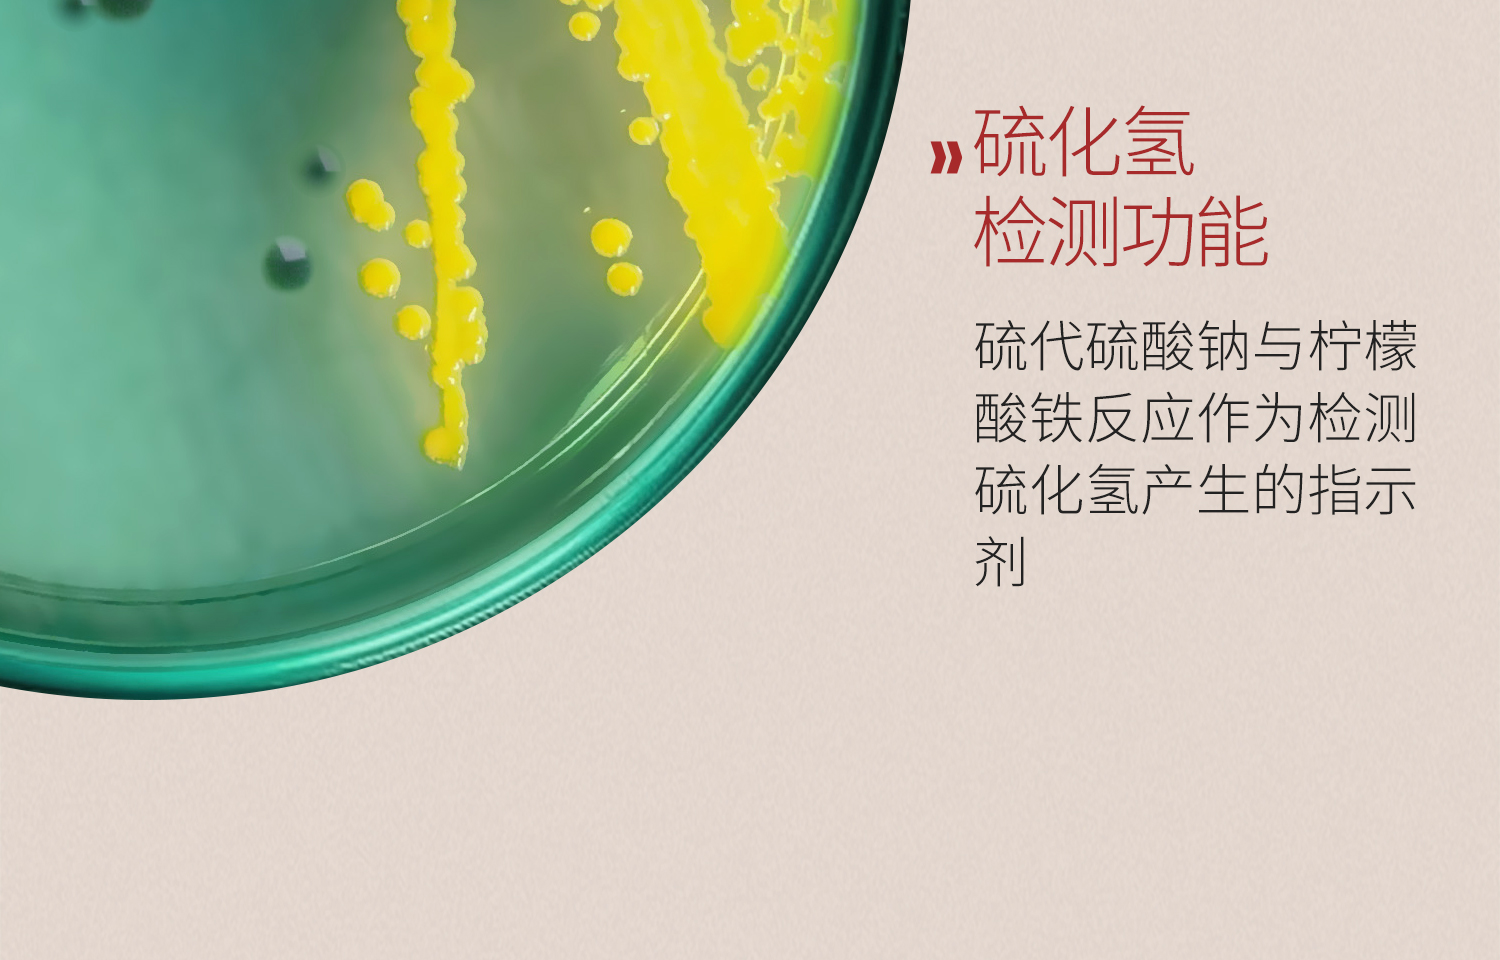
LabTCBS琼脂培养基详情_18.jpg

中文版
English
加入收藏
Labshark TCBS琼脂平板
产品名称:Labshark TCBS琼脂平板
产品品牌:Labshark
产品规格:
-
9cm平板 1个/袋【独立装】 131001004
-
9cm弧菌平板 1包(10个) 131001010